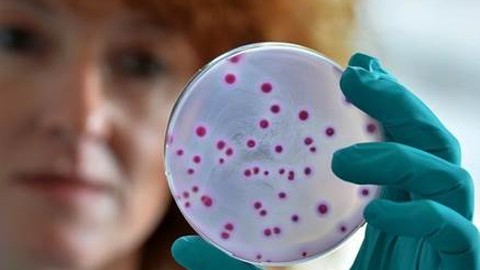
BARMER GEK Arzneimittelreport 2016 deckt Einsparpotenzial in Milliardenhöhe auf

Vorsicht vor Trickbetrügern auf Reisen
Die Reisesaison hat begonnen. Für Reisende bedeutet das erhöhte Achtsamkeit vor Trickbetrügern. Nicht nur „einfache“ Taschendiebe ergreifen im Rummel um die Sehenswürdigkeiten die Chance Bargeld, Kreditkarten oder auch Kameras zu erbeuten, sondern auch Trickbetrüger suchen …
Am 31. Juli endet die Bewerbungsfrist für das „Ausbildungs-Ass“. Der begehrte Preis feiert in diesem Jahr sein 20. Jubiläum. Reichen Sie jetzt Ihre kreativen Ausbildungskonzepte ein!
Service lässt sich nicht testen – ein Irrtum, wie das Deutsche Institut für Service-Qualität (DISQ) seit nunmehr genau zehn Jahren beweist. Das Hamburger Marktforschungsinstitut setzt seit jeher auf aktuelle Messverfahren mit standardisierten und objektivierbaren Kriterien.
Hotel soll komfortablen Arbeitsplatz bieten / Vielreisende mit besonderen Vorlieben - Geschäftsreisen sind kein Spaziergang – deshalb wachsen die Ansprüche an die Unterbringung vor Ort. 98 Prozent der reisenden Arbeitnehmer wünschen sich vor allem ein …
"Was ist bei einer Verletzung durch eine Qualle zu tun?" - Verbraucherfrage der Woche der DKV
Vanessa M. aus Coburg: In einigen Wochen fliege ich ans Meer. An meinem Urlaubsort soll es im Sommer an vielen Stränden Quallen geben soll. Was kann ich tun, wenn ich mit einer Qualle in Berührung …
Die Krankenkasse Knappschaft setzt auf familienfreundliche Zusatzleistungen, die weit über den gesetzlichen Leistungskatalog hinausgehen. Neben dem bekannten AktivBonus-Programm, das sich an die ganze Familie richtet, stehen bei den neuen Leistungen ebenfalls alle Generationen im Fokus.
Die auf Unternehmenssteuerung spezialisierte Managementberatung Horváth & Partners baut ihr Leistungsangebot zur Optimierung der Vertriebsfunktion für Vertriebsmanager weiter aus. Mit der Leitung des entsprechenden Beratungssegmentes wurde der aus den eigenen Reihen kommende Vertriebsexperte Thorsten Lips …
Am 23. Juni startet die Deutsche Inkasso Akademie (DIA) GmbH als erster Weiterbildungsanbieter in Deutschland eine flexible Inkasso-Ausbildung. Mit dem „modularen Sachkundelehrgang“ (mSKL) lässt sich das juristische Fachwissen erwerben, das zwingend für eine Registrierung als …
Nur mal angenommen, Sie würden an einem Abend bis zu neue 29 Kontakte Daten, welche möglicherweise entscheidend oder zumindest förderlich für die Entwicklung Ihres Businesses währen. Würden Sie einen Abend Zeit investieren und sich dieser …
11. Fachkonferenz Reporting am 08. und 09. Juni 2016 in Berlin / Die zunehmende Digitalisierung treibt die Weiterentwicklung der gesamten Unternehmenssteuerung voran. Für das Management Reporting eröffnen sich damit einerseits neue Möglichkeiten, andererseits werden Handlungsbedarfe …
Im Informationszeitalter von heute hat praktisch jeder auf alle verfügbaren Informationen Zugriff und kann damit sehr viele Möglichkeiten und Angebote recherchieren. Das gilt für die Welt der finanziellen Vorsorge genauso wie für andere Bereiche des …
Die POOLS & FINANCE 2016 wird erstmalig von einem umfassenden Kongressprogramm begleitet. Vier Kongresse unter der Regie einiger Mitveranstalter werden die Themen Digitalisierung, Erfolgsformeln für Makler, Baufinanzierung und FinTechs effektiv aufbereiten. Ergänzt wird der „Wissensblock“ …
Wie viel ist ein Autofahrer bereit, für den Konsum von Mehrwertdiensten in einem autonomen Fahrzeug zu zahlen? Dieser Frage haben sich die Managementberatung Horváth & Partners und das Fraunhofer IAO in der gemeinsamen Studie „The …
• Expertenwissen für alle • Ratgeber von der Autobewertung bis zur Vignette • Tipps und Tricks bei der Autopflege / Unter der Überschrift „Wissen tanken“ bietet die neue Website allianz-autowelt.de ein virtuelles Nachschlagewerk für alle …
Diffamierung der Berufsgruppe Pflege!
Die in den letzten Tagen in einem Medien-Hype verbreiteten Informationen zu den Ermittlungen des Bundeskriminalamtes (BKA) zu Betrugsvorwürfen gegen die Berufsgruppe der Pflege veranlassen uns zu dieser Stellungnahme.
Die europäische Kommunikations Kampagne zu den Patientenrechten der grenzüberschreitenden Gesundheitsversorgung startet in Deutschland und in anderen 13 EU-Staaten. Die Initiative wird auf nationaler Ebene von der Bürger Initiative Gesundheit e.V. und auf europäischer Ebene von …